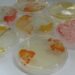

New Delhi: The Indian Junior Women’s Hockey Team is all set to embark on an exciting tour to Argentina for a friendly ‘Four Nations Tournament’, scheduled from 25 May to 2 June 2025.
The team will travel to Rosario in Argentina, where they will play six friendly matches against Argentina, Uruguay, and Chile.
The tournament will begin on May 25, with India playing back-to-back matches against Chile and Uruguay on May 25 and 26, respectively.
After a rest day, they will face hosts Argentina on May 28.
The team will then follow the same sequence in the return leg, taking on Chile on May 30, Uruguay on June 1, and Argentina on June 2.
This tour is a crucial part of the team’s preparations for the FIH Hockey Junior Women’s World Cup, which will take place in Santiago, Chile, in December 2025.
ALSO READ: IPL resumes from May 17; matches to be played across six venues & final on June 3
On the importance of the friendly matches, Indian Junior Women’s Hockey Team Coach Tushar Khandker said, “We are preparing for the Junior World Cup later this year, and since the tour to Rosario is a Four Nations tournament, we are looking to identify the best of the best from this squad with the World Cup in mind.”
He added, “Our aim is to gain as much experience as possible and assess where we stand based on past performances to understand how much we have improved.”